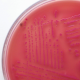

Articles in Tierwelt

Österreich – Wegen eines schweren Verstoßes gegen das Tierarzneimittel- kontrollgesetz und der möglichen Gefährdung der menschlichen Gesundheit wurde ein als Besamungstechniker tätiger Landwirt aus Niederösterreich nun am Bezirksgericht Zwettl strafrechtlich verurteilt:
Bedingte Freiheitsstrafe und fünf Jahre …

London – Sir David Attenborough erhält in Anerkennung seiner bemerkenswerten Fernsehlaufbahn, insbesondere im Bereich der Naturfilme, die Auszeichnung IBC2011 International Honour for Excellence. Seine Laufbahn erstreckt sich über fast 60 Jahre. Sein …

Deutschland – Loriot, bürgerlich Bernhard Victor Christoph-Carl von Bülow, kurz Vicco von Bülow (* 12. November 1923 in Brandenburg an der Havel; † 22. August 2011 in Ammerland am Starnberger See) etablierte sich seit den …

Markersdorf – Am kommenden Wochenende vom 23.-24. Juli 2011 findet im Reitsportzentrum Hiesberger in Markersdorf, Bezirk St. Pölten, wieder ein Horse-Ball Turnier statt.
Die Besucher dieser noch relativ jungen, rasanten und actionreichen Pferdesportart können sich von …

USA – Am 10. Jänner dieses Jahres geboren und schon über 130.000 Fans auf Facebook: Beast the Dog. Was nicht sonderlich verwunderlich ist, sind doch Frauchen und Herrchen wohnhaft in Palo Alto mit Namen Priscilla …

EHEC gehören zu einem geringen Anteil zu den normalen Darmbewohnern von Rindern, Schafen und Ziegen, aber auch Hirschen und Rehen. Diese Tiere erkranken üblicherweise nicht, scheiden den Erreger jedoch über ihren Kot aus.
Menschen können sich …
Deutschland – Seit dem letzten Wochenende grassiert eine gefährliche Darminfektion, die durch den Erreger enterohämorraghische Escherichia coli (EHEC) ausgelöst wird.
Derzeit ist besonders das norddeutsche Gebiet betroffen, aber erste Fälle wurden bereits aus anderen …

Österreich - Die AGES gibt im Auftrag des Bundesministeriums für Gesundheit (BMG) bekannt, dass geringe Mengen von spanischen Gurken, die im Verdacht stehen, mit EHEC-Keimen belastet zu sein können, über deutsche Großhändler auch nach …

USA – Facebook-Chef Mark Zuckerberg (27) ernährt sich fast nur noch vegetarisch. Der Erfinder des größten sozialen Netzwerkes der Welt berichtet dem US-Magazin „Fortune” in einem Interview, dass er sich entschlossen habe, nur noch Fleisch …

Österreich – Ein Tierarztbesuch, wenn eines der Haustiere veterinärmedizinische Hilfe braucht, war in der Hochzeit der Wirtschaftskrise keine Selbstverständlichkeit für so manchen Tierbesitzer. Ein Indiz dafür ist die rege Tätigkeit von Hilfsorganisationen wie die der …